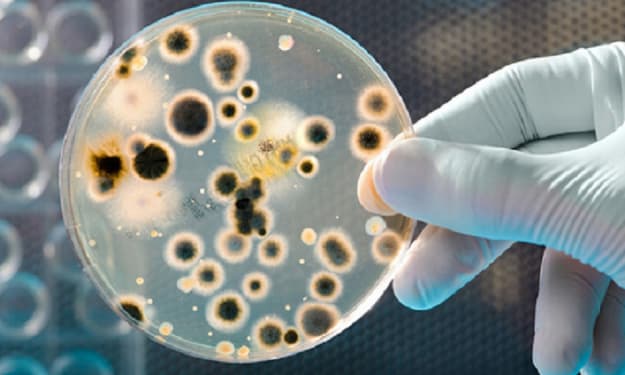

house
Home hacks including DIY organization, storage solutions, cleaning tips and beyond.
About private water wells
Private water wells are generally shallow (less than 200 feet [60 m] deep). They are usually built with solid steel or heavy plastic liners with grooves that allow water to enter. They usually contain underground aqueducts to prevent freezing. More than 15 million households (approximately 15% of North Americans) have private water wells to supply drinking water. Private water wells must be protected from contamination.
By Sara White 6 years ago in Lifehack
North Bangalore – The New Residential Hub
Bangalore as a shining spot for real estate investments due to its assured investment returns, has gained huge importance among the prospective home buyers. Especially, North Bangalore, being a hotbed for investment for quite few years due to multiple considerations has grabbed attention of all IT parks, SEZ and Manufacturing hubs. This may be due to the favorable factors available in the region such as International Airport and excellent connectivity for other prime locales, enhanced infrastructures, and proximity to several IT parks like Ecopolis, Manyata, ITSEZ.
By Nexplace Realty6 years ago in Lifehack
Making A Plan On How To Buy A House
One of the trickiest things you can buy is a house. That’s because a house is a bit expensive. You can’t just go to a store and buy one that fast. That’s the other thing where you need to buy a house that is worth the money that you are paying for. The real estate market is a bit of a broad field where people buy, sell, and rent properties. In the aspect of buying, you need to think before you do so. You need to plan ahead on how you can buy a house.
By garrytaxton6 years ago in Lifehack
City Life Made Simple on Sarjapur Road
Even with the past few months of lockdowns and restrictions, Bangaloreans can still vividly remember the hours they spend stuck in traffic. Real estate in Bangalore is on the rise, seeing innovative projects come up in the form of luxury apartments near Bellandur or 4BHK luxury villas in Chandapura. As the city grows and evolves, where one stays becomes of vital importance. Connectivity is big in a city like Bangalore. Abhee Developers redefines luxury in the city with its latest project – Abhee Nakshatra, 2 & 3BHK luxury apartments on Sarjapur Road.Celebrate a city life that is high on comfort, connectivity, and convenience.
By Nitin Sharma6 years ago in Lifehack
What to consider before getting an Appliance Repair
Living in the modern era is, to a great extent, a blessing. There are dozens of appliances, and others that are invented each day, making our lives so much simpler. Taking this into account, it can be really frustrating when any one of these gadgets malfunctions.
By Paul N. Bush6 years ago in Lifehack
Basement Waterproofing During the COVID-19 Crisis
The hard times we are experiencing nowadays have revealed the most important things we used to neglect before the COVID-19 pandemic breakout. Only the feeling of uncertainty and economic worries have made us consider some more essential issues than those nasty trifles we have always been frustrated about. Certain problems really seemed overpowering; however, they have turned out to be minor ones at the time when we cannot plan things even for the nearest future. The most important idea we have at last realized, painfully though, is - we aren’t ready yet to come across too many unpredictable issues simultaneously.
By Gerge Bens6 years ago in Lifehack
Time To Repair Your Roof? Look For Five Red Flags Before Hiring A Roofer
As a responsible homeowner in Ottawa, you are aware that you need to check your roof’s condition periodically to stay on top of necessary maintenance and repairs. But what and where to look for your roof? Here are five red flags you need to check before hiring a roofer for your home.
By Vincent L. Wexler6 years ago in Lifehack
Some Tips Before You Think to Buy The Best Alarm System For Your House
Once a year, we plan a vacation trip with our family or others. Some even go vacationing every month, but is the fear of your house being unsafe has bothered you while you are out there enjoying? If you feel you are one of those people who want complete security in the house while you are away, then you have come to the right place.
By Kiara Waylen6 years ago in Lifehack
More Efficient Ways to Use the Fireplace for Home Heating
Introduction: In the world, millions of house owners rely on fireplaces, wood stoves, and other heating appliances for fossil fuels to keep their families warm during winter. By failing to understand the value of chimney sweeping, thousands of homeowners sadly earn billions of dollars per year for property harm and accidents.
By Dryer Vent Cleaning6 years ago in Lifehack
5 Tips to Buy the Best-Suited Hardware Reproductions for Your Home
Whether you are aiming to impart a refined Victorian look to your home or need to replace certain hardware to fit it better into your vintage-themed abode, you can do wonders if you choose your hardware reproductions wisely.
By Matthew Shively6 years ago in Lifehack
4 Things You Should Know About Mold Inspection
If you’re thinking how mold can originate into your house then the answer to this is the water that recedes into your house either due to heavy rainfall, or an alarming situation such as a flood. Because flood water is not always clean and bacteria-free we need to make sure it's not causing damage elsewhere. Therefore, for assurance purposes and our health and safety, we need to make sure there are no traces of mold present anywhere in our house.
By Peter Cole6 years ago in Lifehack